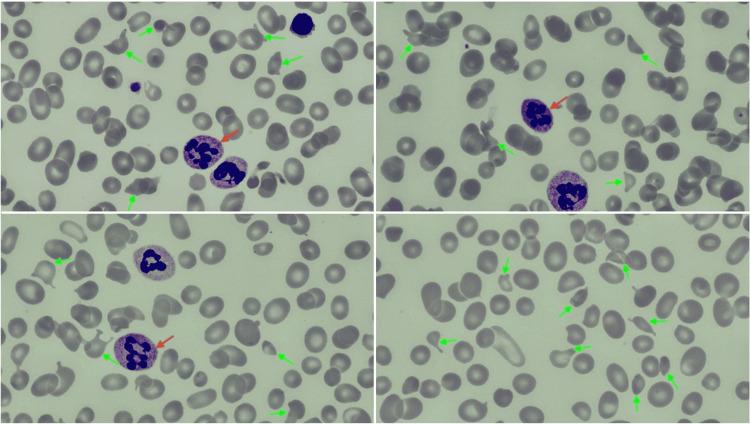

维生素B12缺乏症酷似血栓性血小板减少性紫癜:一例报告及文献复习
Vitamin B12 Deficiency Mimicking Thrombotic Thrombocytopenic Purpura: A Case Report and Review of Literature.
作者信息
Smith-Salzberg Bayle, Homsy Sylvester, Erdinc Burak, Preet Mohan
机构信息
Hematology and Oncology, State University of New York Downstate Health Sciences University, Brooklyn, USA.
出版信息
Cureus. 2024 Jun 29;16(6):e63478. doi: 10.7759/cureus.63478. eCollection 2024 Jun.
Vitamin B12 (cyanocobalamin) deficiency can lead to ineffective erythropoiesis, intramedullary hemolysis, and, in severe cases, neurologic deficits. Some of those findings are also features of thrombotic microangiopathies, specifically thrombotic thrombocytopenic purpura (TTP), and the distinction between both entities could sometimes be challenging. While the treatment of the former consists of enteral or parenteral repletion, the treatment of TTP is more complex and time-sensitive. For that reason, refining diagnostic strategies is crucial to avoid misdiagnosis and unnecessary interventions. Here is an example of a potential life-threatening hemolysis caused by vitamin B12 deficiency with acute onset neurologic symptoms, which resolved with B12 repletion.
维生素B12(氰钴胺)缺乏可导致无效红细胞生成、髓内溶血,严重时可导致神经功能缺损。其中一些表现也是血栓性微血管病的特征,特别是血栓性血小板减少性紫癜(TTP),有时区分这两种疾病具有挑战性。前者的治疗包括肠内或肠外补充,而TTP的治疗则更为复杂且对时间敏感。因此,完善诊断策略对于避免误诊和不必要的干预至关重要。以下是一个因维生素B12缺乏导致急性起病神经症状并伴有潜在危及生命的溶血的例子,补充维生素B12后症状得以缓解。